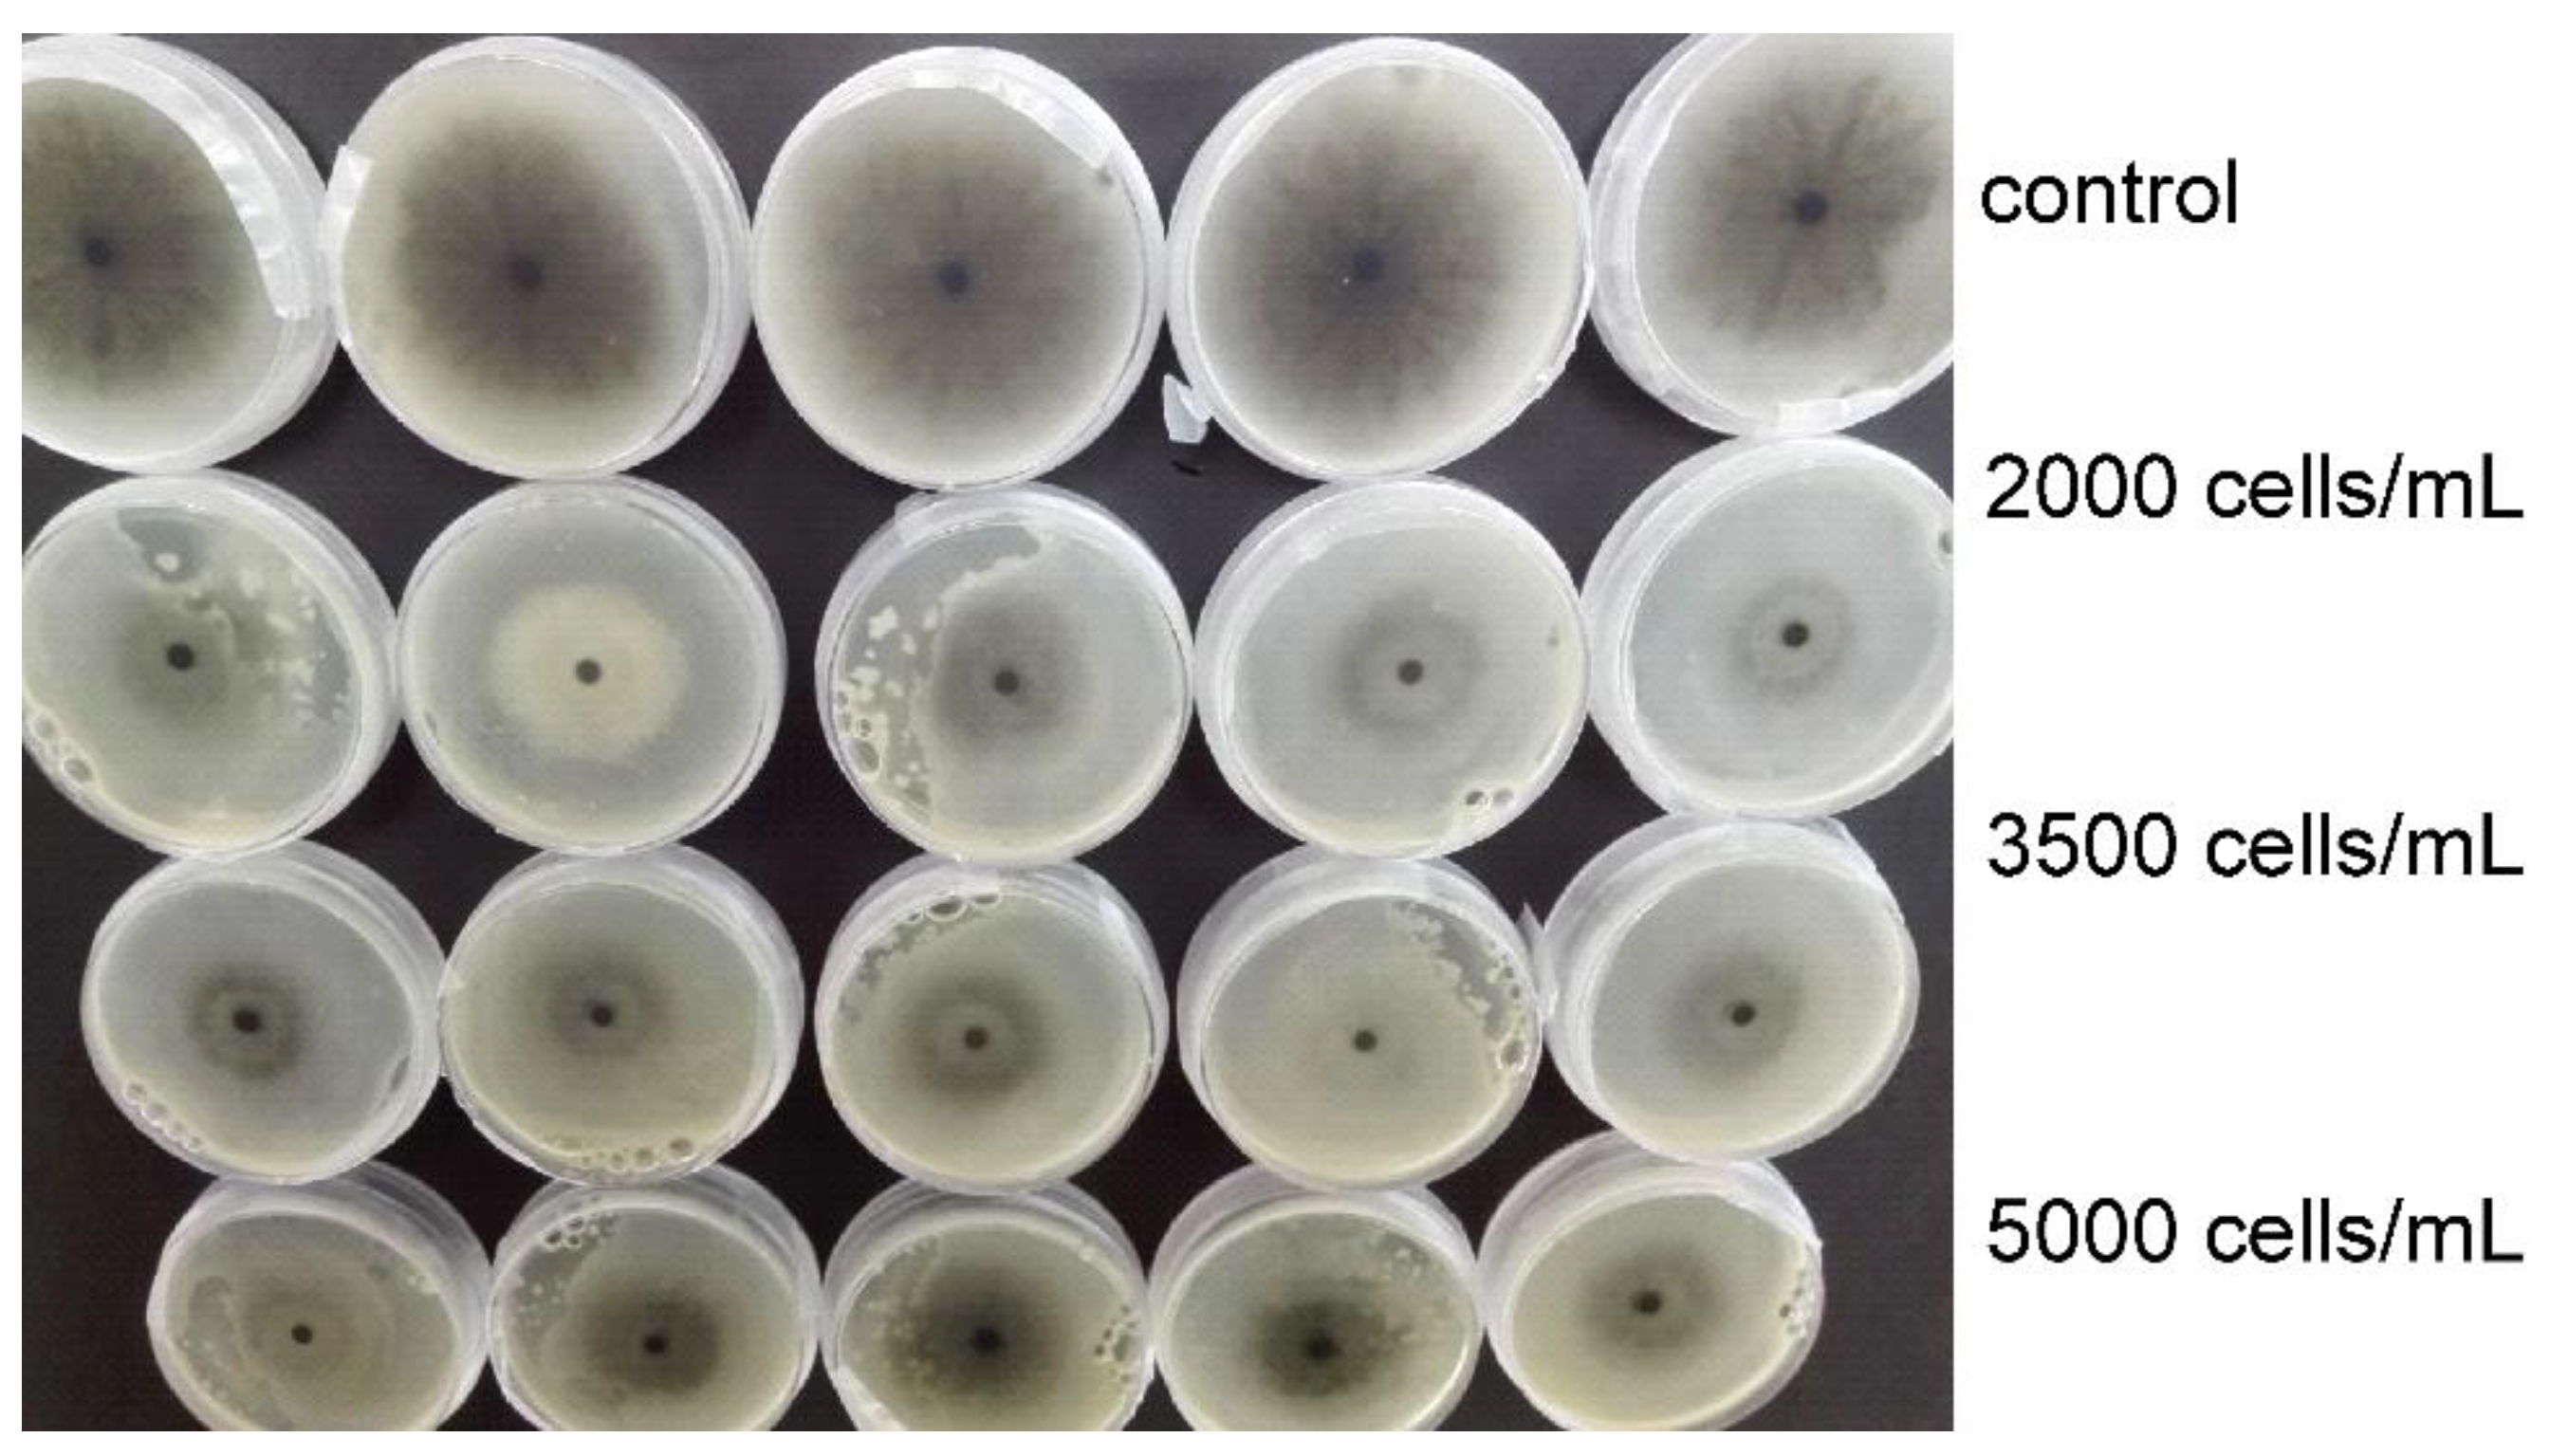
Environments 08 00102 g005 Environments 08 00102 g005

Antifungal Activity of Earthworm Coelomic Fluid Obtained from Eisenia andrei, Dendrobaena veneta and Allolobophora chlorotica on Six Species of Phytopathogenic Fungi
Abstract
1. Introduction
2. Materials and Methods
2.1. Earthworms
2.2. Phytopathogenic Fungi
2.3. Coelomocyte Isolation and Extract Preparation
2.4. Growth Inhibition Test
2.5. Data Analyses
3. Results
4. Discussion
5. Conclusions
Author Contributions
Funding
Institutional Review Board Statement
Informed Consent Statement
Data Availability Statement
Conflicts of Interest
References
- Oerke, E.-C. Crop losses to pests. J. Agric. Sci. 2005, 144, 31–43. [Google Scholar] [CrossRef]
- Khan, S. Macrophomina phaseolina as causal agent for charcoal rot of sunflower. Mycopath 2007, 5, 111–118. [Google Scholar]
- Mondal, B.; Khatua, D.C.; Hansda, S.; Sharma, R. Addition to the host range of Sclerotinia sclerotiorum in West Bengal. Sch. Acad. J. Biosci. 2015, 3, 361–364. [Google Scholar]
- Gondal, A.S.; Rauf, A.; Naz, F. Anastomosis Groups of Rhizoctonia solani associated with tomato foot rot in Pothohar Region of Pakistan. Sci. Rep. 2019, 9, 3910. [Google Scholar] [CrossRef] [PubMed]
- Dreistadt, S.H. Integrated Pest Management for Floriculture and Nurseries; University of California: Los Angeles, LA, USA, 2001. [Google Scholar]
- Van der Plaats Niterink, A.J. Monograph of the Genus Pythium; Centraalbureau voor Schimmelcultures: Baarn, The Netherlands, 1981. [Google Scholar]
- Scherm, B.; Balmas, V.; Spanu, F.; Pani, G.; Delogu, G.; Pasquali, M.; Migheli, Q. Fusarium culmorum: Causal agent of foot and root rot and headblight on wheat. Mol. Plant Pathol. 2013, 14, 323–341. [Google Scholar] [CrossRef]
- Rastija, V.; Vrandečić, K.; Ćosić, J.; Majić, I.; Kanižai Šarić, G.; Agić, D.; Karnaš, M.; Lončarić, M.; Molnar, M. Biological activities related to plant protection and environmental effects of coumarin derivatives: QSAR and molecular docking studies. Int. J. Mol. Sci. 2021, 22, 7283. [Google Scholar] [CrossRef] [PubMed]
- Vraneš, M.; Tot, A.; Ćosić, J.; Papović, S.; Panić, J.; Gadžurić, S.; Janković, N.; Vrandečić, K. Correlation between lipophilicity of newly synthesized ionic liquids and selected Fusarium genus growth rate. RSC Adv. 2019, 9, 19189–19196. [Google Scholar] [CrossRef]
- Panth, M.; Hassler, S.C.; Baysal-Gurel, F. Methods for Management of Soilborne Diseases in Crop Production. Agriculture 2020, 10, 16. [Google Scholar] [CrossRef]
- Fusaro, S.; Gavinelli, F.; Lazzarini, F.; Paoletti, M.G. Soil biological quality index based on earthworm (QBS-e). A new way to use earthworms as bioindicators in agroecosystems. Ecol. Indic. 2018, 93, 1276–1292. [Google Scholar] [CrossRef]
- Bartlett, M.D.; Briones, M.J.; Neilson, R.; Schmidt, O.; Spurgeon, D.; Creamer, R.E. A critical review of current methods in earthworm ecology: From individuals to populations. Eur. J. Soil Biol. 2010, 46, 67–73. [Google Scholar] [CrossRef]
- Byzov, B.A.; Khomyakov, N.V.; Kharin, S.A.; Kurakov, A.V. Fate of soil bacteria and fungi in the gut of earthworms. Eur. J. Soil Biol. 2007, 43, S149–S156. [Google Scholar] [CrossRef]
- Binet, F.; Fayolle, L.; Pussard, M. Significance of earthworms stimulating soil microbial activity. Biol. Fertil. Soils 1998, 27, 79–84. [Google Scholar] [CrossRef]
- Kuzyakov, Y. Priming effects: Interactions between living and dead organic matter. Soil Biol. Biochem. 2010, 42, 1363–1371. [Google Scholar] [CrossRef]
- Bunn, K.E.; Thompson, H.M.; Tarrant, K.A. Effects of agrochemicals on the immune systems of the earthworms. Bull. Environ. Contam. Toxicol. 1996, 57, 632–639. [Google Scholar] [CrossRef]
- Cooper, E.L.; Roch, P. Earthworm immunity: A model of immune competence. Pedobiologia 2003, 47, 319–333. [Google Scholar] [CrossRef]
- Cooper, E.L.; Ru, B.; Weng, N. Earthworms: Sources of antimicrobial and anticancer molecules. Adv. Exp. Med. Biol. 2004, 546, 359–389. [Google Scholar]
- Plavšin, I.; Velki, M.; Ečimović, S.; Vrandečić, K.; Ćosić, J. Inhibitory effect of earthworm coelomic fluid on growth of the plant parasitic fungus Fusarium oxysporum. Eur. J. Soil Biol. 2017, 78, 1–6. [Google Scholar] [CrossRef]
- Bouché, M.B. ; Lombriciens de France. Écologie et Systematique; Institut National de la Rechearche Agronomique: Paris, France, 1972; p. 671. [Google Scholar]
- Rosa, D. Note sui lombrici del Veneto. Atti R. Ist. Veneto Sci. 1866, 4, 673–687. [Google Scholar]
- Savigny, J.C. La multiplicité des espèces de ver de terre. Mem. Acad. Sci. Inst. Fr. 1826, 5, 176–184. [Google Scholar]
- Eyambe, S.G.; Goven, A.J.; Fitzpatrick, L.C.; Venables, B.J.; Cooper, E.L. A non-invasive technique for sequential collection of earthworm (Lumbricus terrestris) leukocytes during subchronic immunotoxicity studies. Lab. Anim. 1991, 25, 61–67. [Google Scholar] [CrossRef]
- Diogené, J.; Dufour, M.; Poirier, G.G.; Nadeau, D. Extrusion of earthworm coelomocytes: Comparison of the cell populations recovered from the species Lumbricus terrestris, Eisenia foetida and Octolasion tyrtaeum. Lab. Anim. 1997, 31, 326–336. [Google Scholar] [CrossRef]
- Engelmann, P.; Kiss, J.; Csöngei, V.; Cooper, E.L.; Németh, P. Earthworm leukocytes kill HeLa, Hep-2, PC-12 and PA317 cells in vitro. J. Biochem. Biophys. Methods 2004, 61, 215–227. [Google Scholar] [CrossRef]
- Friberg, H.; Lagerlöf, J.; Rämet, B. Influence of soil fauna on fungal plant pathogens in agricultural and horticultural systems. Biocontrol Sci. Technol. 2005, 15, 641–658. [Google Scholar] [CrossRef]
- Moody, S.A.; Piearce, T.G.; Dighton, J. Fate of some fungal spores associated with wheat straw decomposition on passage through the guts of Lumbricus terrestris and Aporrectodea longa. Soil Biol. Biochem. 1996, 28, 533–537. [Google Scholar] [CrossRef]
- Guo, Z.; Zhang, X.; Wu, J.; Yu, J.; Xu, M.; Chen, D.; Zhang, Z.; Li, X.; Chi, Y.; Wan, S. In vitro inhibitory effect of the bacterium Serratia marcescens on Fusarium proliferatum growth and fumonisins production. Biol. Control 2020, 143, 104188. [Google Scholar] [CrossRef]
- Aira, M.; Monroy, F.; Domínguez, J.; Mato, S. How earthworm density affects microbial biomass and activity in pig manure. Eur. J. Soil Biol. 2002, 28, 7–10. [Google Scholar] [CrossRef]
- Fiołka, M.J.; Zagaja, M.P.; Piersiak, T.D.; Wróbel, M.; Pawelec, J. Gut bacterium of Dendrobaena veneta (Annelida: Oligochaeta) possesses antimycobacterial activity. J. Invertebr. Pathol. 2010, 105, 63–73. [Google Scholar] [CrossRef] [PubMed]
- Kobayashi, H.; Ohtomi, M.; Sekizawa, Y.; Ohta, N. Biology of lysenin, a protein in the coelomic fluid of the earthworm Eisenia foetida. Int. Rev. Cytol. 2004, 236, 45–99. [Google Scholar]
- Mine, Y.; Kovacs-Nolan, J. Biologically active hen egg components in human health and disease. J. Poult. Sci. 2004, 41, 1–29. [Google Scholar] [CrossRef]
- Bhorgin, A.J.; Uma, K. Antimicrobial activity of Earthworm Powder (Lampito mauritii). Inter. J. Curr. Microbiol. Appl. Sci. 2014, 3, 437–443. [Google Scholar]
- Engelmann, P.; Cooper, E.L.; Németh, P. Anticipating innate immunity without a Toll. Mol. Immunol. 2005, 42, 931–942. [Google Scholar] [CrossRef]
- Fiołka, M.J.; Czaplewska, P.; Macur, K.; Buchwald, T.; Kutkowska, J.; Paduch, R.; Kaczyński, Z.; Wydrych, J.; Urbanik-Sypniewka, T. Anti-Candida albicans effect of the protein-carbohydrate fraction obtained from the coelomic fluid of earthworm Dendrobaena veneta. PLoS ONE 2019, 14, e0212869. [Google Scholar] [CrossRef]
- Cho, J.H.; Park, C.B.; Yoon, Y.G.; Kim, S.C. Lumbricin I, a novel proline-rich antimicrobial peptide from the earthworm: Purification, cDNA cloning and molecular characterization. Biochim. Biophys. Acta Mol. Basis Dis. 1998, 1408, 67–76. [Google Scholar] [CrossRef]
- Chen, H.; Takahashi, S.; Imamura, M.; Okutani, E.; Hang, Z.G.; Chayama, K.; Chen, B.A. Earthworm fibrinolytic enzyme: Anti-tumor activity on human hepatoma cells in vitro and in vivo. Chin. Med. J. 2007, 120, 898–904. [Google Scholar] [CrossRef] [PubMed]
- Kurek, A.; Homa, J.; Kauschke, E.; Plytycz, B. Characteristics of coelomocytes of the stubby earthworm Allolobophora chlorotica (Sav.). Eur. J. Soil Biol. 2007, 43, 121–126. [Google Scholar] [CrossRef]
- Wang, C.; Sun, Z.J. Liu, Y.Q.; Zheng, D.M.; Liu, X.L.; Li, S.Z. Earthworm polysaccharide and its antibacterial function on plant-pathogen microbes in vitro. Eur. J. Soil Biol. 2007, 43, S127–S134. [Google Scholar] [CrossRef]
- Balamurugan, M.; Parthasarathi, K.; Cooper, E.L.; Runganathan, L.S. Anti-inflammatory and ani-pyretic activities of earthworm extract—Lampito mauritii (Kinberg). J. Ethnopharmacol. 2009, 121, 330–332. [Google Scholar] [CrossRef] [PubMed]
- Ansari, A.A.; Sitaram, K. An investigation into the anti-microbial and anti-fungal properties of earthworm powder obtained from Eisenia fetida. Am. J. Food Technol. 2011, 6, 329–335. [Google Scholar] [CrossRef][Green Version]
- Esaivani, C.; Vasanthi, K.; Ranjit Singh, A.J.A. An investigation on antimicrobial potency of coelomic fluid of earthworm Eudrilus eugeniae. Br. J. Med. Health Res. 2017, 4, 2394–2967. [Google Scholar]
- Sethulakshmi, K.C.; Ranilakshmi, K.C. Antifungal potentialities of coelomic fluid of local earthworms against Aspergillus species. Eur. J. Biomed. Pharm. Sci. 2018, 5, 587–591. [Google Scholar]
- Sethulakshmi, K.C.; Ranilakshmi, K.C.; Thomas, A.P. Antibacterial and antifungal potentialities of earthworm Eudrilus eugeniae paste and coelomic fluid. Asian J. Biol. 2018, 5, 1–7. [Google Scholar] [CrossRef]
- Akinnuoye-Adelabu, D.B.; Hatting, J.; Villiers, C.; Terefe, T.; Bredenhand, E. Effect of redworm extracts against Fusarium root rot during wheat seedling emergence. Agron. J. 2019, 111, 2610–2618. [Google Scholar] [CrossRef]
- Fiołka, M.J.; Grzywnowicz, K.; Chlebiej, K.; Szȼzuka, E.; Mendyk, E.; Keller, R.; RZymowska, J. Anti-Candida albicans activity of the glyco-protein complex purified from metabolites of gut bacterium Raoultella ornithinolytica isolated from earthworms Dendrobaena veneta. J. Appl. Microbiol. 2012, 113, 106–119. [Google Scholar] [CrossRef] [PubMed]
- Rajesh, C.; Rajamanikkam, K.; Vadivu, G.N.R.; Palanichelvam, K. Coelomic fluid of earthworm, Eudrilus eugeniae, inhibits the growth of fungal hyphae, in vitro. Int. J. Eng. Adv. Technol. 2019, 9, 2249–8958. [Google Scholar]
- Nadana, G.R.V.; Rajesh, C.; Kavitha, A.; Sivakumar, P.; Sridevi, G.; Palanichelvam, K. Induction of growth and defense mechanism in rice plants towards fungal pathogen by eco-friendly coelomic fluid of earthworm. Environ. Technol. Innov. 2020, 19, 101011. [Google Scholar] [CrossRef]
- Thevissen, K.; Francois, I.E.J.A.; Aerts, A.M.; Cammue, B.P.A. Fungal sphingolipids as targets for the development of selective antifungal therapeutics. Curr. Drug Targ. 2005, 6, 923–928. [Google Scholar] [CrossRef]
- Hua, Z.; Wang, Y.-H.; Cao, H.-W.; Pu, L.-J.; Cui, Y.-D. Purification of a protein from coelomic fluid of the earthworm Eisenia foetida and evaluation of its hemolytic, antibacterial, and antitumor activities. Pharm. Biol. 2011, 49, 269–275. [Google Scholar] [CrossRef] [PubMed]
- Zhang, X.C.; Sun, Z.J.; Zhuo, R.P.; Hou, Q.M.; Lin, G.Q. Purification and characterization of two antibacterial peptides from Eisenia fetida. Prog. Biochem. Biophys. 2002, 29, 955–961. [Google Scholar]

Publisher’s Note: MDPI stays neutral with regard to jurisdictional claims in published maps and institutional affiliations. |
© 2021 by the authors. Licensee MDPI, Basel, Switzerland. This article is an open access article distributed under the terms and conditions of the Creative Commons Attribution (CC BY) license (https://creativecommons.org/licenses/by/4.0/).
Share and Cite
Ečimović, S.; Vrandečić, K.; Kujavec, M.; Žulj, M.; Ćosić, J.; Velki, M. Antifungal Activity of Earthworm Coelomic Fluid Obtained from Eisenia andrei, Dendrobaena veneta and Allolobophora chlorotica on Six Species of Phytopathogenic Fungi. Environments 2021, 8, 102. https://doi.org/10.3390/environments8100102
Ečimović S, Vrandečić K, Kujavec M, Žulj M, Ćosić J, Velki M. Antifungal Activity of Earthworm Coelomic Fluid Obtained from Eisenia andrei, Dendrobaena veneta and Allolobophora chlorotica on Six Species of Phytopathogenic Fungi. Environments. 2021; 8(10):102. https://doi.org/10.3390/environments8100102
Chicago/Turabian StyleEčimović, Sandra, Karolina Vrandečić, Martina Kujavec, Martina Žulj, Jasenka Ćosić, and Mirna Velki. 2021. "Antifungal Activity of Earthworm Coelomic Fluid Obtained from Eisenia andrei, Dendrobaena veneta and Allolobophora chlorotica on Six Species of Phytopathogenic Fungi" Environments 8, no. 10: 102. https://doi.org/10.3390/environments8100102
APA StyleEčimović, S., Vrandečić, K., Kujavec, M., Žulj, M., Ćosić, J., & Velki, M. (2021). Antifungal Activity of Earthworm Coelomic Fluid Obtained from Eisenia andrei, Dendrobaena veneta and Allolobophora chlorotica on Six Species of Phytopathogenic Fungi. Environments, 8(10), 102. https://doi.org/10.3390/environments8100102

